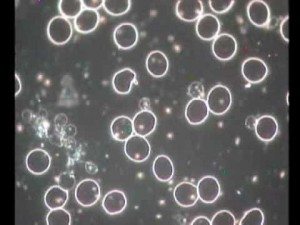
Unhealthy Blood

Over the years I’ve spent a lot of time learning from the worlds best coaches, experts, doctors, scientists, etc. in my quest to be in the best shape and the best health of my life. I’ve sought out the absolute cutting edge thinking in the health and personal fitness industry. It’s amazing what is really out there.
Dr. Robert O. Young is one of the most brilliant microbiologists the world has ever seen. He has discovered that the human body in order to have optimum health free of the common cold, cancer, diabetes, AIDS and other dis-ease requires the body to be in an alkaline state. What is an alkaline state? It’s where 80% of the foods you eat leave an alkaline ash in your body when they are metabolized. The acid forming foods must comprise no more than 20% of your diet.
What’s really shocking is that 95% of the typical American diet consists of acid forming foods. Acid forming meaning the food leaves an acid ash which must be buffered with 80 parts of alkalinity to every 20 parts acid.
What are alkaline forming foods? Almonds, all dark green leafy vegetables, green beans, broccoli, cabbage, collard greens, kale, parsley, celery, cucumbers, green peppers, wheat grass, etc.
What are acid forming foods? All meats such as fish, pork, red meat, hamburger, breads, sugar, candy, most grains, potatoes, dairy, soft drinks, alcohol, chocolate, most nuts, fruit juices which are highly concentrated sugar, etc. Basically all proteins, carbohydrates and especially sugar and refined sugar or high fructose corn syrup. What’s ironic is that sugar which everybody loves, also becomes one of the most toxic and acid forming foods when it is metabolized by your body. It’s not that you should never eat the foods, but it is absolutely essential and a must to ensure that when you eat these foods they only take up 20% of the space on your plate. The other 80% should be comprised of green alkaline producing foods in order to neutralize the acid thereby maintaining the alkaline design and health of your body and its systems.
I sometimes take 1 scoop of Dr. Young’s “pHour Salts” dissolved in a 8 oz glass of water 1-3 times a day depending on how much I have been polluting my body with too much living the good life 😉 I take it 2 hours after a meal. It’s a great supplement to help keep your pH up so your body stays alkaline during the day, especially when you are traveling. When you are worried, stressed or have very negative thoughts, this causes your body to create acid. Your negative thoughts will poison your body literally! I strive to eat healthy 80% of the time, and 20% of the time I will eat junk or have a few drinks. Interestingly, and not by coincidence… it’s also the same ratio of what it takes for 80 parts alkalinity to neutralize 20 parts of acid.
We must also talk about oils. The healthier the oils are, the more toxic they become to your body when they are fried/cooked. What I do is I take 1 tablespoon of Udo’s Oil for every 50 pounds of body weight daily. All of your red blood cells are surrounded by essential fatty acids. What I like about Udo’s Oil is that it is properly balanced with Omega three, Omega six and Omega nine essential fatty acids in the ratios that your body needs. If your body is deficient in essential fatty acids, your red blood cells will stick together in clumps. This makes it very difficult for the nutrients and oxygen to reach all of your cells. Especially in the smallest capillaries and blood vessels. When viewing this under a microscope called dark field microscopy, you can actually see this “logjam” of red blood cells. I don’t care how healthy you think you are, looking at your live living blood can be very sobering. Many athletes and fitness fanatics are very fit, but they are extremely unhealthy. You hear about them all the time. Incredibly fit and amazing looking athletes dropping dead of heart attacks at a young age.
Heart disease and heart attacks are caused by a very acidic diet. When your diet is very acid forming, your body produces cholesterol to line your arteries and blood vessels in order to protect them from the acid in your blood that otherwise would eat holes in your blood vessels and cause you to bleed death internally. Now during normal times when we eat according to what’s in season, typically during the winter we would eat grains and anything that can be stored during the cold winter months when it’s too cold to grow anything. During the summer months we would tend to eat more green vegetables when they are available. Our bodies would return to its alkaline state (during the summer) because of the pH buffers in the greens. The cholesterol which had built up in our blood vessels during the winter months would dissolve and you would pee it out. However, since most people’s diet consists of 95% acid forming foods, the cholesterol will continue to form plaque that eventually clogs the arteries and blood vessels thereby causing strokes, heart attacks and death.
When people get colds, the flu and other illnesses that cause us to have a runny nose, vomit, cold sweats, diarrhea, mucus, etc. it is the body’s way of binding up toxins and acids to get them out of the body and away from your vital organs. Therefore, these illnesses are simply the body’s way of trying to re-balance itself and return to an alkaline state.
What causes people to get fat? As I mentioned in my previous article “death begins in the colon”, I talked about how your body’s cells need three things to thrive and survive: 1) oxygen, 2) the proper nutrients and 3) the ability to eliminate waste. If any one of the three is lacking, your cells will mutate (into cancer cells, rod bacteria, etc.) in order to try to adapt and stay alive in the overly acidic environment. Normally when your body returns to an alkaline state, the cancer cells, rod bacteria, etc. will devolve back into healthy red blood cells. Red blood cells are the building blocks of your body. They form your hair, heart tissue, bone, etc. When your body does not have the energy or nutrients it needs to neutralize the acid, it cannot safely move these toxins and acids out of the body. So it’s only choice is to park them away from the vital organs until (hopefully) your body gets what it needs so it can safely eliminate them. Your body uses fat to bind up toxins and acid.
What’s really disgusting is when you’re able to look at many different peoples living blood under the microscope where you can see cholesterol (which looks like broken glass), red blood cells that have free radical damage (looks like a starburst instead of being perfectly round and smooth), bacteria, parasites, fungus, etc. and you realize that people are literally rotting from the inside out. Because their inner terrain is not balanced and alkaline, the bacteria that exists in every one of us but which is supposed to be mostly dormant, blooms everywhere in your body because bacteria and fungus feed on the excessive amount of glucose/sugar in your blood. This bacteria and fungus is normally what breaks down and decays our body when we die, but unfortunately for most, this bacteria and fungus is rotting their body while they are still alive! People’s bodies wear out and die decades sooner than they should.
Eating the right foods gives your cells the nutrients and building blocks they need. Proper exercise using weights (all of your muscle groups) and cardiovascular training (running, elliptical machines, etc. where you sweat excessively when you do it for 30-45 minutes) moves the lymphatic system (lymphatic system has no pump, it uses expansion and contraction of your muscles to move lymphatic fluid) removing waste and bringing much-needed oxygen and nutrients to your cells. I run for 40-45 minutes 4-5 times per week. I work out with weights 4-5 times per week at a local gym for 15-30 minutes, depending on the body part I am focusing on. Here are my workouts: 1) chest and triceps 2) back and biceps 3) shoulders 4) legs 5) abdominals. Most gyms usually have a few good personal trainers to carefully tailor a program for you. I just maintain my muscle and strength these days. I’m not trying to get bigger like I did when I was younger. Your skin is your biggest organ. When you sweat, your body dumps a lot of toxins and acids. That’s why it is important to shower soon after you complete your workout. Otherwise your skin will simply re-absorb the toxins and acids secreted in your sweat. As long as your colon and your internal sewer system is not clogged, waste can be eliminated from your body.
I have found that the easiest and most efficient way to be alkaline is to juice green vegetables. I have two different types of juicers. When I first started juicing, I bought the Green Star twin gear juicer which cost about $550. The one I use now is the Mack daddy of all juicers. It’s a 100% stainless steel twin gear juicer called the Super Angel Juicer and has a cost of about $2000.
I drink 3 to 4, 24 ounce glasses of juice consisting of a mixture of 50% pure green vegetable juice, and 50% water per day. I like the big plastic 24 ounce tumbler glasses. If you are traveling, Dr. Young also has a powered greens supplement you can take with you called “Doc Broc’s Power Plants.”
This recipe I am about to give you will make four portions of 3/4 of gallon each time you juice of pure green vegetable juice. Each time you go shopping for vegetables to juice, this will last 4 to 6 days for two people, depending on how much you both drink. Each 3/4 gallon will last about 1-2 days for 2 adults. I use empty 1 gallon plastic jugs from bottled water to store my vegetable juice in the refrigerator (only use the jug once. Discard/recycle it after juice is gone). I also reuse BPA free gallon jugs that I sterilize with acid water from the water ionizer after each juice portion is gone. Acid water is great for cleaning. The alkaline water setting on an ionizer will help keep your ph balanced and your body properly hydrated. I have my refrigerator set on 38° to 41°. This keeps the juice at its absolute coldest temperature and away from the air so its enzymes and nutrients can be preserved as long as possible. Here are the ingredients I buy at Whole Foods that will make 4 portions of 3/4 gallon each:
(12) large bundles of organic celery (3 per each 3/4 gallon)
(8) organic large sized fuji apples (2 per each 3/4 gallon portion to sweeten the mixture)
(4) bundles of Lacinato Kale (1 bundle per each 3/4 gallon)
(4) bundles of parsley (1 bundle per each 3/4 gallon)
(4) bundles of collard greens that has 6-8 large leaves (1 bundle per each 3/4 gallon)
(4) 8 ounce bags of precut wheatgrass (1 bag per each 3/4 gallon)
Whats really interesting is that Lacinato Kale has several times more calcium in its juice than milk (kale unlike milk has no lactose or sugar) or any other vegetable. Wheatgrass has over 92 of the known elements (103 total), some just in trace amounts, however, wheatgrass is the most nutrient dense food on the planet. Wheatgrass is also a complete protein and is very high in vitamin C. What’s also interesting is that the blood of plants, chlorophyll is only different from the hemoglobin in your blood by one aspect. Hemoglobin has a central atom of iron. Chlorophyll has a central atom of magnesium.
Another thing that is important to understand about vegetables is that when you cook them and the temperature goes above 118°, it starts to destroy the enzymes and nutrients. What I found when I started eating this way was that it got to be a real pain in the ass to eat salads and other raw vegetables all the time. Juicing green vegetables is a godsend! It’s easy. It’s convenient, and I usually drink my vegetable juice with my meals.
As far as maximizing the nutritional benefit of juicing, and in a perfect world, you would pick your vegetables right from the fields and juice the ingredients drinking the mixture immediately upon completion of the juicing process. When vegetables are juiced (rupturing the cell membranes of the vegetables) this speeds up the breakdown of the enzymes and nutrients. However, by keeping it refrigerated in the temperature range I mentioned above, this is the best alternative I have found to juicing and cleaning up the juicer every time you use it. It takes about 45 minutes from start to finish to make a gallon of juice and clean everything up afterwards with the Super Angel, and about an hour for the Green Star Juicer. I like making juice every other day. For several years I made juice several times a day until I started making it in gallons. I know this is not what Dr. Young recommends, however, I have not noticed any difference other than a little bit of a difference in taste when drinking freshly juiced vegetables versus day-old vegetable juice. It makes my skin softer, I only need 5 to 6 hours of sleep every night, etc. and I don’t get colds or common illnesses that everybody else suffers from any more.
So what has juicing vegetables and eating an alkaline diet done for me personally? Let me give you some of my history of health problems. When I was a kid growing up, our house was always full of junk food, M&Ms, Candy bars, Reese’s Peter butter cups, ice cream, etc. Every morning we would scoop sugar and put it right on our rice crispies cereal. We ate pork, chicken, turkey, steak, bologna, fried foods such as french fries, fried seafood and fried chicken, Pepsi, Coke, etc. Basically, if it was edible, we ate it. Now I was always active as a kid playing football, riding my bike, running and playing etc. but my diet was absolutely atrocious and I suffered for it tremendously.
Every year around the holidays I got the flu. The type of flu were my body produced a green stringy mucus that made you feel like you were trying to blow rubber bands out of your nose. It would take weeks to get over and then two weeks after I was completely over it, I got sick again. Not as bad as the first time, but it still took me several weeks to get better. I constantly had rashes on areas of my skin that itched so bad my skin became raw, scabby and pussy because I was constantly scratching it. These sores sometimes would take over a year to go away, only to pop up on a different part of my body.
I did not understand it at the time, but what I now know is that these sores I had on my skin were just ways my body was trying to get rid of toxins. In middle school I had these raw rashes on the backs of both of my legs that caused me to wake up in the mornings having to peel the sheets off of the back of my legs. While I sat in class during the day my legs would get stuck to the back of my pants. Every time I changed classes I had to pull, or should I say rip my pants unstuck from my scabs. Gross! I also had very bad allergies and hay fever. My nose seemed like it was always running. I was always sniffling and snorting my snot.
I am 5’9” tall and back in 1998 when I was 28 I weighed 190. I was severely constipated and only took a crap a few times per week. When I did, it was like trying to shit a piece of petrified wood. This gave me bad hemorrhoids also. I ate and drank whatever I wanted. I ran 3 to 4 times per week, but I could only run 15 minutes max. I was on the verge of going from a size 33 waist to a size 34.
It was at this point that I started learning how to be a little healthier. I stopped eating red meat, pork, fried foods, soft drinks, and dramatically cut back my sugar intake. This cut out almost 95% of what I was eating. It was really hard at first because most of my diet consisted of crap and extremely acid forming foods. However, within two weeks I ran for 45 minutes and felt like I could run further. That really blew me away. Also, over the next 12 months, I gradually lost the excess weight and got down to 160 pounds. I was not trying to diet per se, I was simply trying to be a lot healthier than I had been. I ate less acid forming foods, and ate more alkaline forming foods without knowing it, as at the time I had never even heard of Dr. Young. I got fewer colds, but I still got sick too often for my liking. I was most happy to take several dumps per day as opposed to 2 to 3 per week. That was a game changer for me! What a relief!
It was not until 2002 when I learned about Dr. Young’s work and started implementing his principles in earnest. I did my first detox and cleanse using the bentonite clay and psyllium husk power mentioned in my article “death begins in the colon”. I could not believe what came out of my body using the supplements. Not only did it stink really bad, but there were all kinds of different colored stuff and mucus that came out. It’s gross and fascinating at the same time. Maybe it’s just a guy thing. We always like to look and see what we made 🙂
Juicing green vegetables will completely change your paradigm! I was very strict about my diet. So much so, that I went five years without getting any headaches, common colds, flu, etc. I only got sick when I got lazy and fell off the wagon so to speak. Last year I took a few months off from exercising and ate too much crap (like Jim Rohn said, “follow what I teach, but don’t follow me too closely.” I’m not perfect). I got skin cancer! A basil cell carcinoma on my neck. I got really strict about my diet and exercise. It made me nervous because after the first 4 weeks nothing changed with my skin cancer. I thought, am I going to have to get this thing cut off? It stopped getting bigger, and then it looked like it was deflating. Pieces of it started dying and falling off. After 8 weeks it was totally gone! My body had healed itself.
Eating an alkaline diet cleared my skin up and made it softer, my eyesight improved, I needed less sleep, my mind was sharper and clearer than it had ever been. I had no more allergies or hay-fever. I now weigh what I weighed in high school, 155-160 and am pretty cut. I still have the body of a high schooler. Some people think I am 25, 28 or 33 usually. I’m 41 (I was just 21 yesterday WTF!!!!!) Until you have experienced it and what it feels like, I might as well be describing what a rose looks, smells and feels like to someone who has never even seen a rose. It’s a night and day difference. Seeing my live living blood under a microscope and being told it was textbook perfect by the blood technician was very rewarding! Hey, by the way, if you can make it until 2045, you will become immortal according to Time Magazine. Your body knows what to do to heal itself. You just need to give it what it needs. Until you live and experience this healthy lifestyle for yourself, you aren’t truly living and experiencing life physically in the way God intended it to be. No words can describe it. Only an experience of it. Try it for 30 days. You can always go back to what you did before. However, if you can motivate yourself to do it for 30 days, you will do it for 6 months. If you can do it for 6 months. You will do it for 2 years. In life you are either a passenger or a pilot, its your choice.
As always, consult your doctor before starting any exercise program, making dietary changes or taking supplements.
Get the Book “How To Be A 3% Man”
*Amazon and the Amazon logo are trademarks of Amazon.com, Inc. or its affiliates. As an Amazon Associate I earn from qualifying purchases. **Free with a new Audible.com membership
*Amazon and the Amazon logo are trademarks of Amazon.com, Inc. or its affiliates. As an Amazon Associate I earn from qualifying purchases.
How to Be a 3% Man
Paperback | $29.99
How to Be a 3% Man
Hardcover | $49.99
How to Be a 3% Man
Paperback | $29.99
How to Be a 3% Man
Hardcover | $49.99
*Amazon and the Amazon logo are trademarks of Amazon.com, Inc. or its affiliates. As an Amazon Associate I earn from qualifying purchases.
Get the Book “Mastering Yourself”
*Amazon and the Amazon logo are trademarks of Amazon.com, Inc. or its affiliates. As an Amazon Associate I earn from qualifying purchases. **Free with a new Audible.com membership
*Amazon and the Amazon logo are trademarks of Amazon.com, Inc. or its affiliates. As an Amazon Associate I earn from qualifying purchases.
Mastering Yourself
Paperback | $49.99
Mastering Yourself
Hardcover | $99.99
Mastering Yourself
Paperback | $49.99
Mastering Yourself
Hardcover | $99.99
*Amazon and the Amazon logo are trademarks of Amazon.com, Inc. or its affiliates. As an Amazon Associate I earn from qualifying purchases.
Get the Book “Quotes, Ruminations & Contemplations”
*Amazon and the Amazon logo are trademarks of Amazon.com, Inc. or its affiliates. As an Amazon Associate I earn from qualifying purchases. **Free with a new Audible.com membership
*Amazon and the Amazon logo are trademarks of Amazon.com, Inc. or its affiliates. As an Amazon Associate I earn from qualifying purchases.
Quotes, Ruminations & Contemplations
Paperback | $49.99
Quotes, Ruminations & Contemplations
Hardcover | $99.99
*Amazon and the Amazon logo are trademarks of Amazon.com, Inc. or its affiliates. As an Amazon Associate I earn from qualifying purchases.
If you have a question you would like me to consider answering in a future Video Coaching Newsletter, you can send it (3-4 paragraphs/500 words max) to this email address: [email protected]
If you feel I have added value to your life, you can show your appreciation by doing one of the following three things:
- Make a donation to my work by clicking here to donate via PayPal anytime you feel I have added significant value to your life. You tip your favorite bartender, right? How about a buck... $2... $3... $5... $10... $20... what ever YOU feel its worth, every time you feel I have given you a good tip, new knowledge or helpful insight. Please feel free to donate any amount you think is equal to the value you received from my eBook & Home Study Course (audio lessons), articles, videos, emails, newsletters, etc.
- Referring your friends and family to this website so they can start learning and improving their dating and relationship life, happiness, balance and overall success in every area of their lives too!
- Purchase a phone/Zoom (audio only) coaching session for yourself or a friend by clicking here. Download the Amazon.com Kindle version of my book to your Kindle, Smartphone, Mac or PC for only $9.99 by clicking here. Get the iBook version for $9.99 from the iBookstore by clicking here. Get the Audio Book for FREE $0.00 with an Audible.com membership by clicking here or buy it for $19.95 at Amazon.com by clicking here. Get the iTunes Audio Book for $19.95 by clicking here. That way, you'll always have it with you to reference when you need it most. Thank you for reading this message!
From my heart to yours,

Corey Wayne
Author, Speaker, Peak Performance Coach, Entrepreneur
“The doctor of the future will give no medicine but will interest his patients in the care of the human frame, in diet, and in the cause and prevention of disease.” – Thomas Edison
In 400 B.C., Hippocrates, the father of all doctors, said, “let your medicine be your food, and let your food be your medicine.”
Some Books I Highly Recommend To Educate Yourself:

matt ruhland says
This is an awesome article! I also love your videos and your book. You should consider doing a video on nutrition. Maybe even one where you show us how you make your drinks and other tips. Thanks Corey, you’re the best!
Elvis from Africa says
Thank you Corey Wayne. I’m a big follower of your work and is lifechanging. I lost lots of weights, have become more focused in my career and getting better with women. Thank you life saver